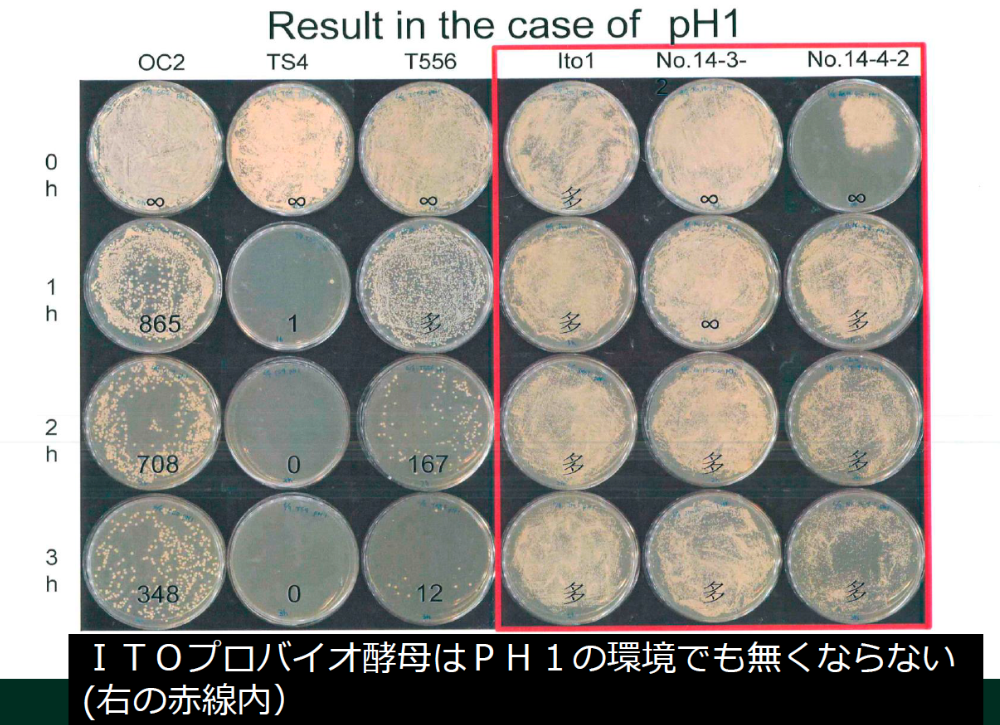

食事の我慢ができない「カロリーオーバー」状態と、食事制限できてたとしても「代謝」が悪いので痩せない。これは痩せるセオリー最悪の状態です。そんな時は、ダイエットスイッチを ON にしましょう。

人間の腸内には様々な「菌」が存在します。
デブ菌=【ファーミキューテス菌】
・代謝を悪くし、消化されたものを溜め込む性質があります。
・排出力が落ちて脂肪や老廃物を溜め込んでしまいます。
痩せ菌=【バクテロイデス菌】
・余分な栄養の吸収を制御し、脂質代謝をアップさせます。
・交感神経やホルモンに影響し食欲をコントロール。